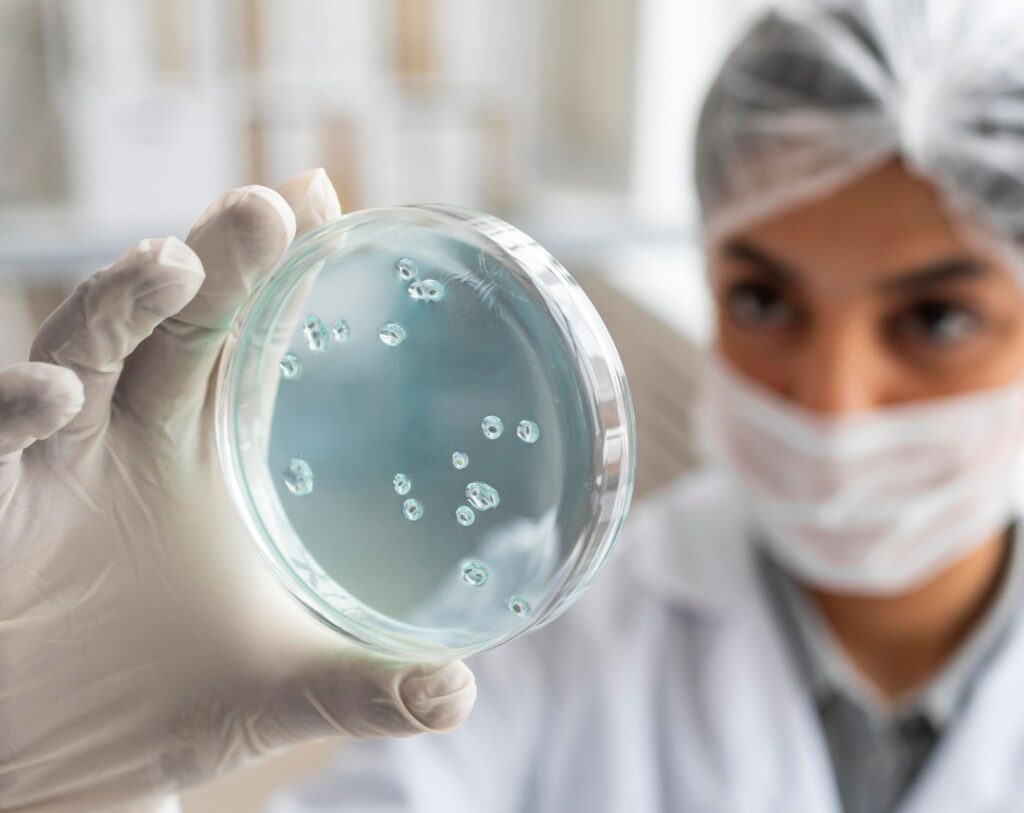

Estudios Área Médica
Estudios Clínicos
Tu salud, nuestro enfoque especializado
En Laboratorios Valdés ofrecemos estudios clínicos organizados por especialidad médica. Esto nos permite brindar soluciones precisas para cada necesidad de salud, con profesionales expertos y tecnología de punta.
Estudios Clínicos
Hematología
¿Sientes cansancio, mareos o infecciones recurrentes? Nuestros estudios de hematología permiten evaluar la calidad y cantidad de tus células sanguíneas. A través de pruebas como la Biometría Hemática (BH), TP y TTP, detectamos anemia, alteraciones en la coagulación e infecciones.
Este análisis es esencial para diagnósticos tempranos y seguimiento de múltiples enfermedades.
- Personas con síntomas de anemia (cansancio, palidez, debilidad).
- Pacientes que serán sometidos a cirugías.
- Personas con sangrados frecuentes o moretones sin causa aparente.
- Seguimiento de tratamientos médicos.

Como funciona
• Se obtiene una muestra de sangre mediante una punción en la vena del brazo.
• Se analiza la cantidad y calidad de glóbulos rojos, glóbulos blancos y plaquetas.
• Incluye pruebas de coagulación como TP y TTP.
• Permite detectar anemia, infecciones y problemas en la coagulación.
• Resultados disponibles en poco tiempo para diagnóstico oportuno.
Indicaciones previas
• Generalmente no requiere ayuno, salvo indicación médica.
• Informar si se toman medicamentos anticoagulantes.
• Evitar ejercicio intenso 24 horas antes.
• Mantener buena hidratación.
• Consultar a tu médico sobre la frecuencia recomendada del estudio.
¿Por qué realizarlo con nosotros?
• Equipo especializado en hematología clínica.
• Resultados confiables y rápidos.
• Tecnología de última generación para precisión diagnóstica.
• Acompañamiento médico en la interpretación de resultados.
• Atención personalizada y sin largas esperas.

Estudios Clínicos
Bioquímica clinica
Conoce el estado general de tu organismo con estudios como QS6, Perfil Metabólico 15 o 35, y Hemoglobina A1c. Estos análisis evalúan la función de órganos vitales como hígado, riñones y páncreas, además de ayudarte a detectar y controlar la diabetes y desórdenes metabólicos.
¿Quiénes deben realizarse este estudio?
- Pacientes con sospecha o diagnóstico de diabetes.
- Personas con antecedentes familiares de enfermedades metabólicas.
- Quienes buscan un chequeo preventivo integral.
- Pacientes bajo tratamiento médico que requieren monitoreo de órganos.
Como funciona
• A través de un análisis de sangre se miden parámetros metabólicos.
• Incluye pruebas como QS6, Perfil Metabólico 15/35 y Hemoglobina A1c.
• Evalúa función hepática, renal, pancreática y metabólica.
• Permite detectar diabetes, alteraciones del colesterol y enfermedades hepáticas.
• Ofrece una visión integral del estado de salud.
Indicaciones previas
• Ayuno de 8 a 12 horas antes del análisis.
• Evitar alcohol y comidas copiosas 24 horas previas.
• Mantener hidratación con agua.
• Informar medicamentos en uso.
• Realizar en la mañana para mayor exactitud.
¿Por qué realizarlo con nosotros?
• Equipo especializado en hematología clínica.
• Resultados confiables y rápidos.
• Tecnología de última generación para precisión diagnóstica.
• Acompañamiento médico en la interpretación de resultados.
• Atención personalizada y sin largas esperas.
Estudios Clínicos
Inmunología
¿Dolores articulares, fatiga o inflamación persistente? Los estudios de inmunología detectan alteraciones en el sistema inmunitario y ayudan al diagnóstico de enfermedades autoinmunes. Incluyen pruebas como perfil reumático, anticuerpos antitiroideos y anticuerpos antinucleares.
¿Quiénes deben realizarse este estudio?
- Pacientes con sospecha de enfermedades como lupus, artritis reumatoide o tiroiditis autoinmune.
- Personas con síntomas de inflamación crónica.
- Personas con sangrados frecuentes o moretones sin causa aparente.

Como funciona
• Se obtiene una muestra de sangre mediante una punción en la vena del brazo.
• Se analiza la cantidad y calidad de glóbulos rojos, glóbulos blancos y plaquetas.
• Incluye pruebas de coagulación como TP y TTP.
• Permite detectar anemia, infecciones y problemas en la coagulación.
• Resultados disponibles en poco tiempo para diagnóstico oportuno.
Indicaciones previas
• Generalmente no requiere ayuno, salvo indicación médica.
• Informar si se toman medicamentos anticoagulantes.
• Evitar ejercicio intenso 24 horas antes.
• Mantener buena hidratación.
• Consultar a tu médico sobre la frecuencia recomendada del estudio.
¿Por qué realizarlo con nosotros?
• Equipo especializado en hematología clínica.
• Resultados confiables y rápidos.
• Tecnología de última generación para precisión diagnóstica.
• Acompañamiento médico en la interpretación de resultados.
• Atención personalizada y sin largas esperas.

Estudios Clínicos
Endocrinología
El equilibrio hormonal es clave para tu salud. Nuestros estudios incluyen perfil tiroideo, perfil hormonal femenino/masculino, cortisol y HGC, útiles para evaluar el sistema endocrino y la fertilidad.
¿Quiénes deben realizarse este estudio?
- Mujeres y hombres con problemas de fertilidad o desequilibrio hormonal.
- Pacientes con síntomas de alteraciones tiroideas (cansancio, cambios de peso, caída de cabello).
- Personas con estrés crónico que necesitan evaluar cortisol.
- Mujeres en control de embarazo o planeación familiar.
Como funciona
• Se mide la concentración de hormonas en sangre.
• Incluye perfil tiroideo, perfil hormonal femenino/masculino, cortisol y HGC.
• Evalúa el equilibrio endocrino y su impacto en la salud.
• Detecta problemas de fertilidad, tiroides y estrés crónico.
• Se utiliza para diagnóstico, control y seguimiento médico.
Indicaciones previas
• Algunos análisis requieren ayuno de 8 a 12 horas.
• Informar uso de hormonas o anticonceptivos.
• Evitar ejercicio intenso el día previo.
• Realizar la prueba en el horario indicado por el médico.
• Consultar si debe suspenderse algún medicamento antes del estudio.
¿Por qué realizarlo con nosotros?
• Equipo especializado en hematología clínica.
• Resultados confiables y rápidos.
• Tecnología de última generación para precisión diagnóstica.
• Acompañamiento médico en la interpretación de resultados.
• Atención personalizada y sin largas esperas.
Estudios Clínicos
Microbiología
Si sospechas de una infección, los cultivos microbiológicos (orina, heces, faringe, semen, esputo, vaginal, entre otros) y el antibiograma permiten identificar microorganismos y seleccionar el tratamiento más efectivo.
¿Quiénes deben realizarse este estudio?
- Pacientes con infecciones urinarias, respiratorias o digestivas recurrentes.
- Mujeres con molestias ginecológicas persistentes.
- Pacientes que requieren un tratamiento antibiótico personalizado.
Como funciona
• Se analiza una muestra (orina, heces, secreciones, esputo, semen, etc.).
• El cultivo permite identificar bacterias, hongos o parásitos.
• El antibiograma determina el tratamiento más eficaz.
• Útil para diagnóstico de infecciones recurrentes.
• Brinda un resultado preciso y dirigido.
Indicaciones previas
• Seguir las instrucciones específicas según el tipo de muestra.
• No automedicarse antes de la prueba.
• Recolectar la muestra en frasco estéril.
• Entregar la muestra lo antes posible tras la recolección.
• Informar al personal sobre tratamientos antibióticos recientes.
¿Por qué realizarlo con nosotros?
• Equipo especializado en hematología clínica.
• Resultados confiables y rápidos.
• Tecnología de última generación para precisión diagnóstica.
• Acompañamiento médico en la interpretación de resultados.
• Atención personalizada y sin largas esperas.

Estudios Clínicos
Gastroenterología
Nuestros estudios de citología fecal, sangre oculta en heces, Helicobacter pylori y panel viral ayudan a detectar infecciones intestinales, problemas digestivos y riesgo de cáncer gastrointestinal.
¿Quiénes deben realizarse este estudio?
- Pacientes con dolor abdominal, diarreas o estreñimiento crónico.
- Personas con antecedentes familiares de cáncer de colon o estómago.
- Quienes presentan pérdida de peso inexplicada o sangrado en heces.
Como funciona
• Se mide la concentración de hormonas en sangre.
• Incluye perfil tiroideo, perfil hormonal femenino/masculino, cortisol y HGC.
• Evalúa el equilibrio endocrino y su impacto en la salud.
• Detecta problemas de fertilidad, tiroides y estrés crónico.
• Se utiliza para diagnóstico, control y seguimiento médico.
Indicaciones previas
• Algunos análisis requieren ayuno de 8 a 12 horas.
• Informar uso de hormonas o anticonceptivos.
• Evitar ejercicio intenso el día previo.
• Realizar la prueba en el horario indicado por el médico.
• Consultar si debe suspenderse algún medicamento antes del estudio.
¿Por qué realizarlo con nosotros?
• Equipo especializado en hematología clínica.
• Resultados confiables y rápidos.
• Tecnología de última generación para precisión diagnóstica.
• Acompañamiento médico en la interpretación de resultados.
• Atención personalizada y sin largas esperas.

FAQ
Sí, si tienes síntomas dirigidos (por ejemplo: fatiga, problemas digestivos, síntomas hormonales), tu médico puede sugerir un área médica específica.
Puedes solicitar una o varias dentro del área médica. Muchos pacientes optan por paquetes completos.
Depende del tipo de prueba; la mayoría entre 24 y 48 horas.
Sí, ofrecemos repetición a solicitud del médico para confirmar diagnósticos con garantía.
¡Ponte en contacto con nosotros!
Comunícate con nosotros usando el formulario de consulta o los datos de contacto que aparecen a continuación.


© 2025 Created with LabvaldesMKT